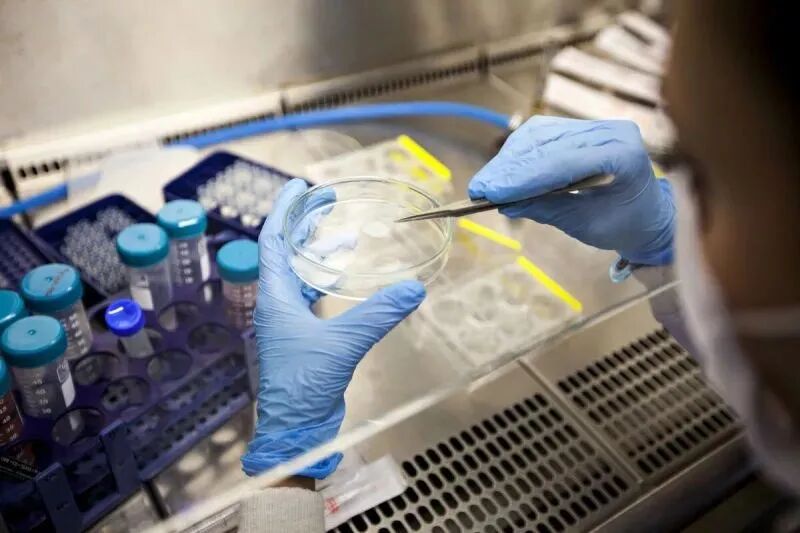
ͼƬ

|

干细胞具有很强的增殖能力,是一种可以分化为不同细胞类型的自我维持细胞群。间充质干细胞有极强的自我更新和多向分化潜能,还具有低免疫原性和免疫调节性 ,是最具有潜力的研究对象。基于其独特的生物学特性,现在被用于治疗各种创伤性和退行性疾病,其临床应用潜能几乎是无限的。

利用干细胞治疗眼科疾病的进展
根据2020年世界卫生组织发布的首份《世界视力报告》,目前全球有超过24亿人视力受损或失明,其中有10亿人是因近视、远视、干眼,角膜疾病、视网膜、视神经疾病黄斑变性、眼外伤等疾病,并且许多导致失明的疾病目前很难治疗。
针对不同眼疾的现代治疗方法的开发和引入是医学上的一大挑战。近年来,眼科专家已经在干细胞研究上投入了大量的关注。

治疗干眼
干眼(DED)是眼科门诊最常见的疾病,其主要特征是泪膜不稳定和高渗透的恶性循 环所导致的眼表炎症、损伤以及眼部异物感。中至重度的DED会伴有明显的疼痛,导致患者生活质量下降,甚至产生抑郁等心理问题。

DED发病机制复杂,病因繁多
目前认为眼局部的炎症免疫反应是引起干眼病理损害的重要机制,相应的抗炎治疗是研究的热点。当炎症在发病机制中起关键作用时,干细胞可用于治疗包括DED在内的许多眼表疾病。
在眶内注射刀豆蛋白a的干眼综合征中探究了干细胞的治疗潜力。
结果表明,干细胞可减少CD4+细胞浸润,降低眼眶内腺体和眼表面炎性细胞因子水平。此外,干细胞刺激了泪液的形成,显著增加了结膜杯状细胞的数量。有效降低眼表炎症指数、延长BUT、减少FLS、修复角膜上皮;同时,干细胞回输组与阳性对照组,结膜杯状细胞数量及泪液分泌量明显增多。因为炎症微环境对干细胞的归巢生存至关重要。
(点击识别查看详情)
治疗角膜疾病
目前角膜病是引起视力丧失的第二位主要病因。
临床上通常将各种原因导致的眼表疾病的终末阶段统称为角膜缘干细胞功能障碍(LSCD),会发生角膜上皮反复剥脱、角膜上皮结膜化、角膜新生血管、角膜混浊等临床改变,严重威胁着患者的健康, 最终导致视力丧失。

LSCD的治疗一直是临床上的一大难题,近年来干细胞羊膜的开展明显提高了成功率。研究人员等建立兔角膜缘干细胞缺损模型以探讨无缝线干细胞羊膜在兔角膜缘干细胞缺损模型的应用效果。
随机分为三组:实验组(A组) 行无缝线干细胞羊膜治疗,阳性对照组(B组)行单纯羊膜术,阴性对照组(C组)不做手术处理。A、B两组术后28d。
实验结果表明无缝线BMSCS羊膜治疗能有效预防兔角膜缘干细胞缺乏,且炎症反应小,角膜透明度高。
治疗视网膜和视神经疾病
近几年有人提出干细胞治疗可作为治疗视网膜和视神经变性的有效方法。
已经探知干细胞对视网膜神经节细胞具有保护作用,并通过分泌旁分泌因子刺激视神经轴突的再生。
作用机制
干细胞通过直接分泌神经营养因子,或刺激可在激活后提供额外旁分泌供应并能起细胞替代作用的内源性细胞,为视网膜受损细胞轴突神经的保护和再生提供营养供应。
干细胞给药如今已成为治疗糖尿病视网膜病变 (DR) 的方法之一。

干细胞治疗DR的机制
向视网膜细胞分化、抑制视网膜新生血管形成、分泌神经营养因子、分化成胰岛素分泌细胞以降低血糖、抑制炎症反应及免疫调节作用等 。
一项临床初步试点研究显示,在观察视网膜下间隙干细胞治疗增生性糖尿病视网膜病变(PDR)的治疗中,通过4例系列病例追踪观察,结果显示,所有患者在成功接受治疗后均未出现任何全身及眼部不适。表明视网膜下间隙干细胞治疗PDR 是相对安全的,回输的干细胞发挥了局部抗炎的作用,未发现细胞的增生反应及循环改善效果 。
治疗黄斑变性
相关性黄斑变性(ARMD)是老年人群中最常见的致盲原因。
ARMD分为干性ARMD和湿性ARMD2种类型,目前临床上对于ARMD的治疗主要针对湿性ARMD伴发的脉络膜新生血管(CNV),而对于干性 ARMD尚无有效的治疗方法。在ARMD的演变过程中,RPE细胞首先受到损害,进而使光感受器细胞(视锥、视杆细胞)等发生退行性改变 。

James等研究表明,用含成纤维细胞生长因子、表皮细胞生长因子及脑源性神经营养因子的条件培养基与RPE细胞培养液体外共培养后,干细胞能够诱导分化成光感受器样细胞。在人体视网膜退行性病变 的临床模型中显示,干细胞对感光细胞具有保护作用。
作用机制
主要与神经营养因子 (NTF)释放而引起的旁分泌效应有关,NTF可参与调节神经系统中神经元和其他细胞的生长、功能与存活。因此,目前认为BMSCS治疗ARMD是通过分泌细胞因子(CK) 和NTF而对受体细胞产生积极影响,并由免疫调节活性改变神经退行性变过程 。
8例干型ARMD和黄斑营养 不良的患者接受干细胞治疗第2阶段结果显示,所有患者没有眼部或全身并发症,且视力均得到了提高。
治疗眼外伤
眼睑烧伤是眼外伤中最严重的化学性损伤,由于各种手术本身均有一定的局限性,传统的羊膜在临床应用中受到一定的限制。目前,干细胞治疗眼表损伤模型已取得较好的效果。
干细胞以旁分泌作用发挥其抗炎和抗血管生成的功效。
研究表明将干细胞在结膜下注射,可促进角膜上皮再生、减少炎症和新生血管,并增加抗炎细胞因子的表达。
综述所述
总的来说,大量科学研究已将干细胞引入了眼科临床实践并不断深化,为细胞水平的治疗提供了巨大的机会,突出了干细胞在眼科学乃至整个生物学进化中的重要研究价值,在不久的将来,干细胞能够治愈更多的眼疾,让各种眼疾就能像白内障那样容易得被移除了,给眼疾患者带来光明。
上海本正生物工程有限公司提供的干细胞是从脐带、胎盘中提取的一种修复器官机理的未完全分化的原始细胞,具有自我更新、多项分化和高度繁殖的能力,医学上称为“万能细胞”,它是形成人体各种组织器官的起源细胞。干细胞对临床上一些疑难疾病的治疗如:脑瘫、老年痴呆、脑萎缩、帕金森病、中风、肝硬化、糖尿病、红斑狼疮、股骨头坏死、软骨和关节损伤、心脏和脊髓损伤等,取得显著效果,它拥有更加鲜活细胞能量,可以快速、有效进入体内,分泌多种有益细胞因子,调节体内微环境,激活干细胞再生能力,重启时光之门,追溯青春绽放源头,实现对人体衰老状态减缓,同时有效改善身体亚健康以及预防肿瘤发生。

|
